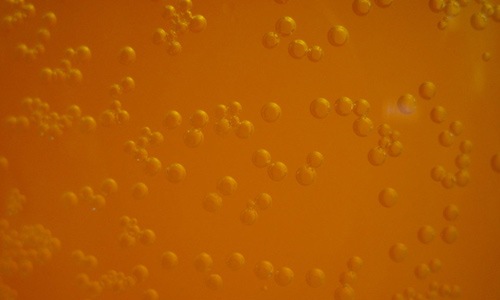

30 бесплатных текстур с пузырьками
22 июля 2011 | Опубликовано в Веб-дизайн | Нет комментариев »
Игривый вид пузырьков освежает, бодрит и радует глаз. Почему бы тогда не украсить ими вашу работу? Они могут стать отличным фоном или элементом дизайна.
В этой подборке вам представлены 33 текстуры с изображением различных пузырьков. Тут вы найдете пену, пузырьки во льду, красочные и яркие пузырьки в высоком разрешении. Все они абсолютно бесплатны.
Сферы
Доступна в разрешении 2592×1944 px.
Воздушные сферы
Доступна в разрешении 2592×1944 px.
Пузыри
Доступна в разрешении 2816×2112 px.
Пена
Доступна в разрешении 3872×2592 px.
Пивные пузырьки
Доступна в разрешении 3264×2448 px.
Пузыри
Доступна в разрешении 3264×2448 px.
Темно-желтые пузырьки
Доступна в разрешении 3264×2448 px.
Крупные пузыри
Доступна в разрешении 2000×1500 px.
Бульбы
Доступна в разрешении 2000×1500 px.
Мыльные пузыри
Доступна в разрешении 3648×2736 px.
Красные пузырьки
Доступна в разрешении 2816×2112 px.
Крупные красные пузырьки
Доступна в разрешении 2816×2112 px.
Мелкие красные пузырьки
Доступна в разрешении 2816×2112 px.
Пузырьки разных размеров
Доступна в разрешении 2816×2112 px.
Светлые пузыри
Доступна в разрешении 2816×2112 px.
Крупные пузыри на темном фоне
Доступна в разрешении 2816×2112 px.
Пузырьки на темном фоне
Доступна в разрешении 2816×2112 px.
Мелкие пузырьки
Доступна в разрешении 2816×2112 px.
Пузыристый лед
Доступна в разрешении 2800×2100 px.
Пузыри на воде
Доступна в разрешении 2560×1707 px.
Необычные пузырьки
Доступна в разрешении 2865×2082 px.
Пузырьки на бледном фоне
Доступна в разрешении 2865×2082 px.
Бульбы
Доступна в разрешении 2865×2082 px.
Розовые пузырьки
Доступна в разрешении 2865×2082 px.
Пузыри на золотом фоне
Доступна в разрешении 2865×2082 px.
Крупные золотые пузыри
Доступна в разрешении 2865×2082 px.
Мыльные пузыри
Доступна в разрешении 3648×2736 px.
Темно-синие пузыри
Доступна в разрешении 3264×2448 px.
Пузырьки на голубом фоне
Доступна в разрешении 3264×2448 px.
Пузыри различных размеров
Доступна в разрешении 3264×2448 px.
Яркие голубые пузырьки
Доступна в разрешении 3264×2448 px.
Красно-золотые пузыри
Доступна в разрешении 2048×1211 px.
Разноцветные пузыри
Доступна в разрешении 3264×2448 px.
Автор — naldzgraphics
Перевод — Дежурка